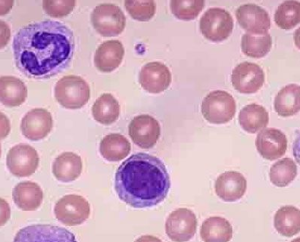
ph染色體是慢性髓系白血病特徵性

定義
 ph染色體
ph染色體原理
 ph染色體陰性
ph染色體陰性另外,在前體B細胞和T細胞腫瘤,即急性淋巴母細胞白血病/淋巴瘤中,約3%的兒童及25%的成人也檢出費城染色體。
作用
ph染色體是慢性髓系白血病特徵性
ph染色體是慢性髓系白血病特徵性在慢性粒細胞白血病中,約90%以上CML患者有一種異常染色體,即第22號染色體的一條長臂缺失,缺失部分易位到9號染色體之一長臂末端。即t(9q+,22q-)。
缺失長臂的22號染色體稱為費城染色體即ph染色體(PhiladelphiaChromosome,ph')。
Ph染色體的形成機理是t(9;22)(q34;q11)
Ph染色體還可見於患者的其他系列細胞(如幼紅細胞、巨核細胞及淋巴細胞等)Ph染色體陽性患者的預後比陰性者差。
5%的CML有BCR-ABL融合基因陽性,而ph染色陰性。

